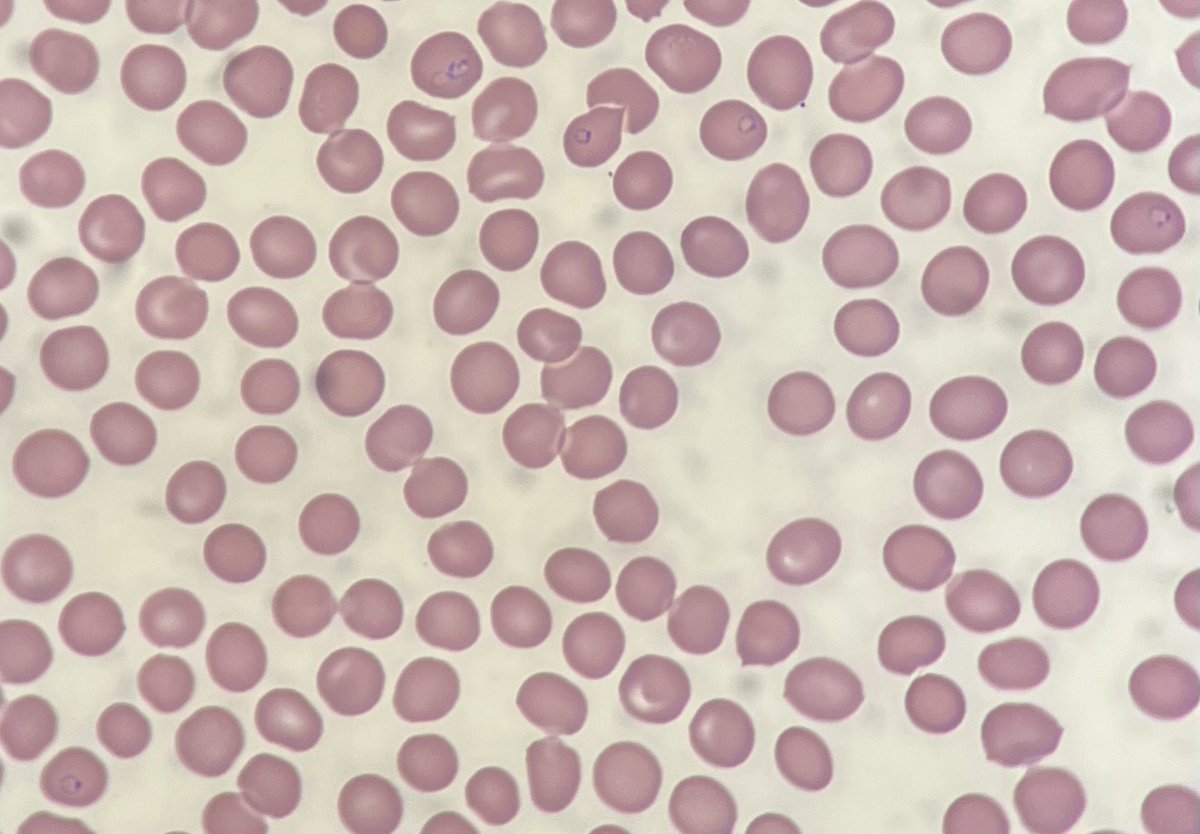
En primicia desde la guardia de hematología: 38 años, fiebre de 39,2ºC, náuseas y vómitos, recién llegado de Costa de Marfil… y este frotis

Juanjo M. Marcuartu
@jjmarcuartu
Seran tus pasos, no el camino, los que te llevarán al final.
Melómano, cinéfilo y Médico Nuclear, no por ese orden necesariamente.
ID: 8885342
14-09-2007 21:29:55
5,5K Tweet
145 Followers
320 Following



Situado en San Francisco con foto de Nueva York con el magnífico e inigualable Empire State Building saludando la tremenda cagada de La Vanguardia El rascacielos de los “millonarios” que se está inclinando y temen que acabe derrumbándose lavanguardia.com/cribeo/fast-ne…

🎖¡Estamos de enhorabuena! La Unidad de #Digestivo del Hospital Universitario de Jaén ha recibido la Medalla de Bronce al Mérito Social Penitenciario que otorga Instituciones Penitenciarias del Ministerio del Interior ¡Felicidades, equipo!










Curso avanzado SIRT. Desengranando la Radioembolización con el gran equipo multidisciplinar del H. Gregorio Marañón Sirtex Medical





🇪🇸 𝗡𝗔𝗗𝗔𝗟𝗖𝗔𝗥𝗔𝗭 🇪🇸 Rafa Nadal 🤝 Carlos Alcaraz #Wimbledon


Primer preceptorship en Hepatocarcinoma al Hospital Universitari Bellvitge | HUB !! Benvinguts!! Maria Rosa Rota Roca Mariona Jose Castellote